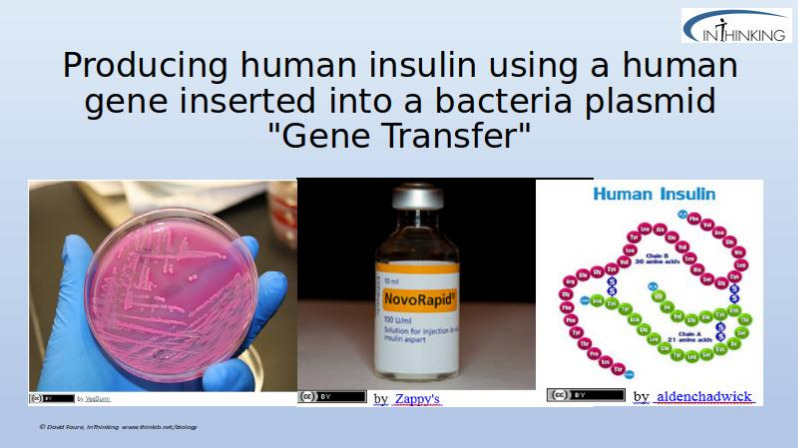

Genetically Modified Organisms.
Enzymes used in Gene transfer and the Risks and Benefits of GMOs
In an excellent BBC interview with some anti-GMO protesters destroying a field of research crops some young people were asked to explain why they were taking this action. None of those interviewed could explain what the risks of GMO crops are. The field represented years of research by a geneticist trying to find new crop varieties to feed a growing world population. The young protesters had a right to protest but also, a duty to understand why they were doing it. In this lesson students learn an outline of the basic technique used for gene transfer involving plasmids, in bacteria. Looking at a number of examples of GMOs they research the potential benefits and possible harmful effects of of genetic modification.
Lesson Description
Guiding Questions
The DNA code is "universal" how does this help gene transfer?
What is the difference between a bacterial chromosome and a plasmid?
Activity 1 Making a GMO - online animation
DNA is universal: a piece of DNA code forms the instructions to make the same protein in any living organism.
It is possible to put a gene for human insulin into a bacterial cell and the bacterium will produce insulin.
Use this
animation on making insulin to help you make introductory notes about the use of genetically modified bacteria to make human insulin. See the video clip preview below.
The details of two enzymes used in this process are included in the slides below.
Activity 2: Benefits and risks from GMOs
Carry out research on risks and benefits of GMOs using the links below or your text book.
Complete structured notes using the worksheet below.
Activity 3 IB Style questions on GMOs
Try answering the following questions.
Teachers notes
Time for this series of activities 1h - 2hr
The first activity should be accompanied with a link to the idea that the genetic code is universal.
The animation could be shown to the whole class, but it's good to allow students time to replay the details afterwards if necessary. This animation is very clear but it misses the details of the enzymes.
The slides give these details and give a simple overview of the roles of the two enzymes.
Students can record the method of making insulin by gene transfer in E.coli on the first page of the worksheet.
The web link gallery provides a good range of sources of information, but to save time directing students to a single resource is possible.
The student worksheet provides a space to record structured notes about the benefits and potential risks.
There is a TOK style question on the worksheet, 'Do GMO protesters make the world a safer place?' This topic could make a good TOK presentation topic, and it could include reference to reason and emotion as ways of knowing. Scientists sue reason to evaluate their results, and emotion has a role at least in their motivation to work. In protesters there is plenty of reasoning and emotion too. Why do the two groups see things so differently?
Other links
Animation on making insulin
Student worksheet for structured notes
IB Style questions on Gene transfer
The final activity is a couple of summative questions, which could be set as homework.
There are Gene transfer - Model Answers here.
IB Docs (2) Team